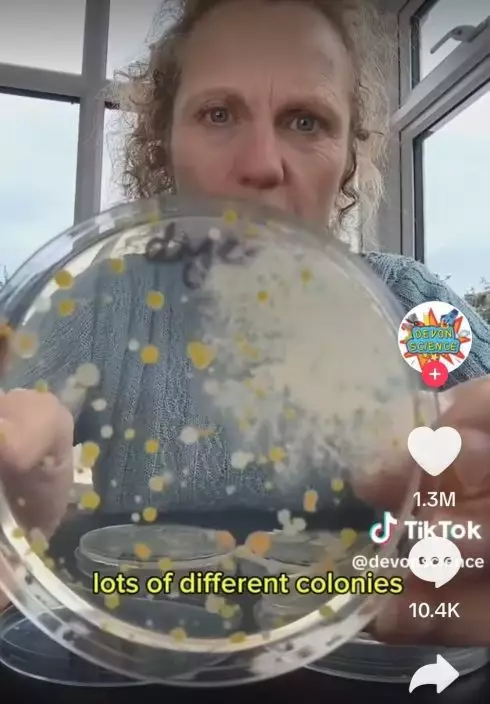
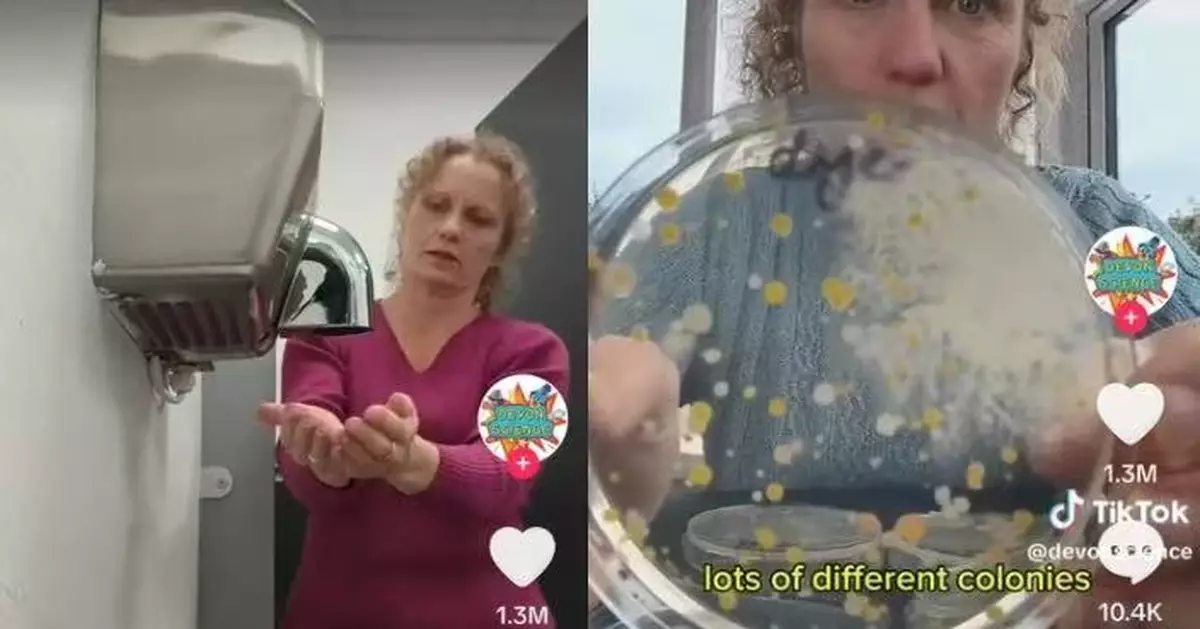
英實驗揭公共廁所烘手機吹出大量細菌真菌 噁心畫面曝光

英國科學家實驗揭驚人真相,指公共廁所烘手機吹出大量細菌真菌震驚網民,不少人表示再也不敢用!
@devonscience Has anything changed? Did that hand dryer get a service or clean? For its viral birthday 🎉 (28M views), I went back and retested THE hand dryer seen by so many, this time I also tested my hands before & after using it. I've identified the main bacterial species growing (they're common environmental bacteria), and they're coming from inside the machine vents (see videos on this). Please see my follow up videos on this which will answer some of your questions, i.e. are the bacteria harmful, what do these results mean, what happens next! Remember this is a quick test, not a scientific experiment, but it could be a great project for someone studying microbiology. I've tested a few different hand dryers over the last 12 months, have a look at the videos on my profile. #handdryer #bacteria #viral #germs #dirty ♬ original sound - Devon Science
科學家實驗揭「烘手機」細菌驚人
日前,英國一名科學家兼教育計劃創辦人露絲・麥克拉倫(Ruth MacLaren)於TikTok上分享一項簡單卻震撼的實驗過程顯示,公共廁所的烘手機會吹出大量細菌與真菌。麥克拉倫將培養皿放於公共廁所烘手機下方,收集吹出的空氣樣本,同時以另一個培養皿在一般空氣中揮動作為對照。
經過一夜培養,結果顯示烘手機樣本中布滿細菌與真菌,而普通空氣樣本則幾乎為零。她對此直言:「這就是我不用烘手機的原因。」相關影片隨即在網上瘋傳,引起熱烈討論。

科學家做實驗揭公共廁所烘手機吹出大量細菌真菌。影片截圖
網民驚呼連連
影片曝光後,網民紛紛留言表示震驚與反感,有人留言稱,「我寧願用衣服擦手,因為我不喜歡烘手機的噪音」、「太誇張了,明明沒有直接接觸烘手機,這些細菌從哪來的?我以為高溫會殺死細菌,以後不敢用烘手機了」、「身為一個多年來一直宣傳烘手機很髒的人,我覺得自己不那麼瘋狂了」。

科學家做實驗揭公共廁所烘手機吹出大量細菌真菌。影片截圖
實驗存變數 科學家承諾再測
也有網民指出實驗設計存在疏失,認為應以公廁內的空氣作對照,而非辦公室空氣。麥克拉倫事後在回應中承認此問題,並表示將進一步進行更嚴謹的測試,以驗證烘手機是否真為「細菌溫床」。
科學家做實驗揭公共廁所烘手機吹出大量細菌真菌。影片截圖